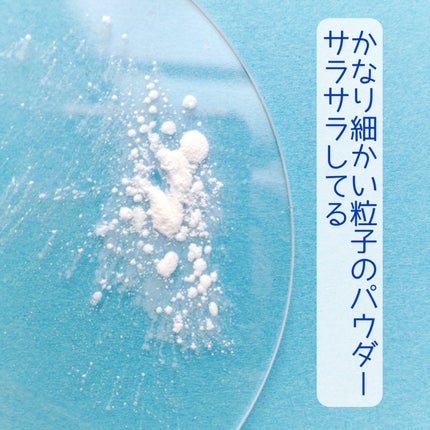
トランスルーセントセットフィニッシングパウダー/TFIT/ルースパウダーを使ったクチコミ(8枚目)

付けた時からサラすべの質感になり、毛穴目立ちを和らげるポイントは変わりません。 色味はほとんど付かないのですが、自分の肌色にワントーン明るめのフィルターをかけたような仕上がりが特長的でした。 ナチュラルな仕上がりがお好みの方には向いているかもしれません。
もっと見るルースパウダーランキング
| 商品画像 | 商品情報 | 参考価格 | 評価 | ランキングIN | 特徴 | 商品リンク |
|---|---|---|---|---|---|---|
SHISEIDO SHISEIDO エッセンス スキンセッティング パウダー | 5,500円 |
| フェイスパウダーランキング第1位 | パウダーが軽いのでほんとつけていることを 忘れてしまうような薄膜感な仕上がりでした | 詳細を見る | |
DECORTÉ ルース パウダー | 6,270円 |
| フェイスパウダーランキング第3位 | とにかくお粉がふわっふわでサラサラで良い❤️ | 詳細を見る | |
GIVENCHY プリズム・リーブル | 8,250円 |
| フェイスパウダーランキング第4位 | パール配合でツヤっとした肌に✨ナチュラルなんだけど品があってこのツヤがとってもキレイなの🥺 | 詳細を見る | |
SUQQU ザ ルース パウダー | 11,000円 |
| フェイスパウダーランキング第13位 | 細かなピンクっぽいラベンダーっぽい粒子が フワッと密着してくれて 柔らかな顔の印象になる | 詳細を見る | |
ByUR セラムフィット ルースフェイスパウダー | 2,090円 |
| フェイスパウダーランキング第17位 | 顔がテカりやすく毛穴が気になる方にはぴったりです!片栗粉のようにサラッサラで、粒子がかなり細かいです✨ | 詳細を見る | |
DECORTÉ フェイスパウダー | 5,500円 |
| フェイスパウダーランキング第15位 | 溢れ出るツヤ感がとっても綺麗で、透明感のある仕上がりに◎ふわりサラリと軽やかな触り心地! | 詳細を見る | |
キャンメイク シルキールースモイストパウダー | 968円 |
| フェイスパウダーランキング第18位 | ヴェールをまとったようなサラサラのお肌になるのが個人的高ポイント🌟 | 詳細を見る | |
innisfree ノーセバム ミネラルパウダー N | 899円 |
| フェイスパウダーランキング第20位 | フィルターをかけたような肌になり毛穴も目立ちにくくしてくれます🌞 プチプラだし、 使い切りしやすいサイズ感◎ | 詳細を見る | |
クレ・ド・ポー ボーテ プードルトランスパラントn | 13,200円 |
| フェイスパウダーランキング第22位 | 粉の繊細さが増したと感じられファンデーションで作ったつや肌もきちんと残してくれて 「めちゃくちゃ良い…!」と心が躍りました♪ | 詳細を見る | |
Wonjungyo ウォンジョンヨ フィクシングブラーパウダー N | 1,980円 |
| フェイスパウダーランキング第21位 | 繊細パウダーで、ふんわりとなめらか肌に仕上げてくれます。 | 詳細を見る |
cherrygirl🍒さんの人気クチコミ
このコラボは本気でズルすぎん?? JOOCY✕Chupa Chups [Sweet Heart]シリーズ Qoo10で一目惚れして完全パケ買い😍 ※()内の商品名はサイトごとに微妙に違っています…😅 可愛すぎて使えないのでしばらく観賞用になりそうです✨️ メッチャ使いたいという気持ちもあるんですがね💦
もっと見る
429
129
- 2024.10.08
このアンティークルビーは免れるんじゃ、なんて淡い期待をしておりましたが、期待は崩れさり、悲しい現実…😭😭😭 CANMAKEさん、のんびりしてると棚の商品が売り切れなくても撤去されるから気を付けないと💦 だって、CANMAKEさんの現行のパレットでここまでピンク(レッド?)が強いのはこのパレットだけだから…⤵️
もっと見る
378
82
- 2023.09.03
\新作の舞台はアリス/古典文学からインスピレーションを受けたヴィーガンメイクアップブランドのDinto。次の舞台は『不思議の国のアリス』、『鏡の国のアリス』からインスピレーションを受けたコレクションだよ🪞・GlowingTimetoKiss&...
もっと見る
316
57
- 2025.05.19
【私のガチ推し!!】青み吸収しちゃう方や、少し青みを足したい方に♡ChacottマルチカラーバリエーションマットMA22¥1,320(税込)✼••┈┈••✼••┈┈••✼••┈┈••✼••┈┈••✼このMA22を仕込むだけで大分変わるよ✨️プ...
もっと見る
280
74
- 2025.05.02
この初期のレトロなキティちゃんが1番好き…🩷 背面にはミミィちゃんまで居るし💕 雑誌は…ゴメン、120%付録買い😂 正直なところ、ネイルケアのツールとしてどこまで使えるかは謎😅 キティちゃんっていうところに意味がある😂
もっと見る
256
37
- 2024.08.12
プチプラのクオリティじゃないっ!! 発売前からチェックしていたけれど、ここまで可愛いとは…😆 絶妙カラーで目もとのくすみを飛ばして*明るい印象に🩷 横割りグラデーションでメイクし、立体感をより出したかったので最後に1番左のカラーを上まぶたの真ん中と涙袋にのせています🙆 肌馴染みも良くて粉飛びも感じにくかったです💕 ブラウンの方も店頭に出てたら買おうかな💓
もっと見る
244
24
- 2025.02.07
商品詳細情報TFIT トランスルーセントセットフィニッシングパウダー
- ブランド名
- TFIT(ティーフィット)
- ランキングIN
- 全体ランキング年代別ランキングフェイスパウダー 10代 第53位フェイスパウダー 20代 第53位フェイスパウダー 30代 第53位フェイスパウダー 40代以上 第53位ルースパウダー 10代 第25位ルースパウダー 20代 第25位ルースパウダー 30代 第25位ルースパウダー 40代以上 第25位肌質別ランキング
- 容量・参考価格
- 7g: 1,760円
- ミニ(3.5g): 1,188円
- バリエーション
- 01 ホワイト(White)
- 02 スキンベージュ(Skin Beige)
- 03 グリーン(Green)
- 04 ラベンダー(Lavender)
- 05 ベビーピンク(Baby Pink)
- 01ホワイト ミニ
- 商品説明
- テカリ・毛穴レス*1肌印象へ導く超微粒子パウダー。超微粒子のパウダーが毛穴をぼかし、皮脂を吸着することで油分を抑えメイクアップの持続性を高めます。 また、タルクフリー、保湿成分として17種のアミノ酸*2、加水分解コラーゲン、宝石パウダー*3を配合。 *1メイクアップ効果による *2グリシン、セリン、グルタミン酸、アスパラギン酸、ロイシン、アラニン、リシン、アルギニン、チロシン、フェニルアラニン、プロリン、トレオニン、バリン、イソロイシン、ヒスチジン、システイン、メチオニン *3アメジスト末、ダイヤモンド末、サファイア末
- メーカー名
- TFIT CLASS INC.
- 発売日
- 2023/9/15(最新発売日: 2025/6/2)
- 成分
- <01 ホワイト(White)> シリカ、オクテニルコハク酸デンプンAl、(ジメチコン/ビニルジメチコン)クロスポリマー、合成フルオロフロゴパイト、トリ(カプリル酸/カプリン酸)グリセリル、ヘキサ(ヒドロキシステアリン酸/ステアリン酸/ロジン酸)ジペンタエリスリチル、水、BG、モモ花エキス、加水分解コラーゲン、加水分解エラスチン、アラントイン、グリシン、セリン、アラニン、アスパラギン酸、リシン、グルタミン酸、アルギニン、ロイシン、プロリン、チロシン、フェニルアラニン、バリン、イソロイシン、トレオニン、ヒスチジン、システイン、メチオニン、1,2-ヘキサンジオール、ジメチコン、カプリル酸グリセリル、アメジスト末、ダイヤモンド末、パール、サファイア末、PCA-Na、ベタイン、ソルビトール、トコフェロール、香料 <02 スキンベージュ(Skin Beige)> シリカ、オクテニルコハク酸デンプンAl、(ジメチコン/ビニルジメチコン)クロスポリマー、合成フルオロフロゴパイト、トリ(カプリル酸/カプリン酸)グリセリル、ヘキサ(ヒドロキシステアリン酸/ステアリン酸/ロジン酸)ジペンタエリスリチル、水、BG、モモ花エキス、加水分解コラーゲン、加水分解エラスチン、アラントイン、グリシン、セリン、アラニン、アスパラギン酸、リシン、グルタミン酸、アルギニン、ロイシン、プロリン、チロシン、フェニルアラニン、バリン、イソロイシン、トレオニン、ヒスチジン、システイン、メチオニン、1,2-ヘキサンジオール、ジメチコン、カプリル酸グリセリル、トリエトキシカプリリルシラン、アメジスト末、ダイヤモンド末、パール、サファイア末、ベタイン、PCA-Na、ソルビトール、トコフェロール、酸化鉄、香料
![LIPS[リップス] - コスメのクチコミ検索アプリ](https://cdn.lipscosme.com/assets/lips_logo_full_2022-bc7b4bc9dd66035bc5696b0d16bc3d38a7be357186656c039e68cc4cf21ae675.png)

いい感じだねー!厚みがあると悩ましいけど思ったより大きくなさそう😍